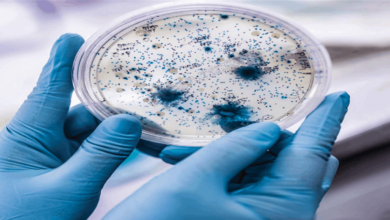

حمى “لاسا”… اليكم بعض المعلومات حولها

وتم تسجيل 3 حالات مؤكدة من حمى لاسا بهذه البلاد خلال الأسبوع الماضي، وفقا لما نقل تقرير للكاتب بروس واي لي في فوربس Forbes عن وكالة الأمن الصحي بالمملكة المتحدة “يو كيه إتش إس إيه” (UKHSA). وتوفي أحد هؤلاء في مستشفى لوتون ودنستابل الذي تديره مؤسسة خدمات الصحة الوطنية لمستشفيات بيدفوردشير.
وتم الإبلاغ عن 8 حالات فقط في المملكة المتحدة منذ عام 1980، ولم يتم الإبلاغ عن أي حالات منذ الإبلاغ عن حالتين عام 2009.
تقول الدكتورة سوزان هوبكنز، كبيرة المستشارين الطبيين بوكالة الأمن الصحي لدى “يو كيه إتش إس إيه” إن الحالات سجلت ضمن نفس العائلة “وهي مرتبطة بسفر إلى غرب أفريقيا”.
إنها متوطنة في أجزاء من غرب أفريقيا مثل بنين وغانا وغينيا وليبيريا ومالي وسيراليون وتوغو ونيجيريا. ووفقا للمراكز الأميركية للسيطرة على الأمراض والوقاية منها (CDC) هناك ما يقدر بنحو 100 ألف إلى 300 ألف من حالات الإصابة بهذه الحمى على مستوى العالم، وتؤدي إلى وفاة حوالي 5 آلاف شخص.
ما مرض حمى لاسا؟
حمى لاسا مرض نزفي فيروسي حاد يدوم فترة تتراوح بين يومين و21 يوما، وفقا لمنظمة الصحة العالمية.
ورغم وصف الفيروس المسبب لهذه الحمى لأول مرة في الخمسينات، لم يتم التعرف عليه حتى عام 1969. وهو أحد الفيروسات ذات حمض الرنا الوحيد الجديلة Single-stranded RNA وينتمي لفصيلة الفيروسات الرملية virus family Arenaviridae.
كيف ينتقل للإنسان؟
ينتقل فيروس لاسا إلى الإنسان عن طريق ملامسة الأغذية أو الأدوات المنزلية الملوثة ببول القوارض أو برازها.
ويمكن أن تنتقل العدوى أيضا من شخص إلى آخر وفي المختبرات، ولا سيما في المستشفيات التي تفتقر إلى تدابير كافية للوقاية من العدوى ومكافحتها.
أين يوجد؟
من المعروف أن حمى لاسا متوطنة في بنين وغانا وغينيا وليبيريا ومالي وسيراليون ونيجيريا، لكن يحتمل وجودها أيضا في بلدان أخرى غرب أفريقيا، وفقا لمنظمة الصحة.
ما معدل الإماتة؟
يبلغ معدل الإماتة الإجمالي 1%. أما معدل الإماتة الملاحظ لدى المصابين بحالات حمى لاسا الوخيمة بالمستشفيات فيبلغ 15%. وتحسن الرعاية الداعمة المبكرة، عن طريق تعويض السوائل ومعالجة الأعراض، فرص البقاء على قيد الحياة.
ولا تظهر الأعراض على حوالي 80% من المصابين بالعدوى بفيروس لاسا. وتسبب حالة واحدة كل 5 حالات للعدوى الإصابة بمرض وخيم، إذ يصيب الفيروس عدة أعضاء مثل الكبد والطحال والكلى.
ما المستودع الحيواني للفيروس؟
لاسا مرض حيواني المصدر مما يعني أن الإنسان يصاب بالعدوى نتيجة لمخالطة حيوانات مصابة. والمستودع الحيواني أو المضيف لفيروس لاسا هو قارض ينتمي إلى جنس المستوم الذي تشيع تسميته “الجرذ عديد الأثداء”. ولا تصاب مثل هذه الجرذان نتيجة للعدوى بفيروس لاسا، غير أنها يمكن أن تخرج الفيروس في بولها وبرازها، وذلك وفقا لمنظمة الصحة.
ما الأعراض؟
تتراوح فترة حضانة حمى لاسا بين 6 و21 يوما. وإذا كان المرض مصحوبا بالأعراض، فيبدأ ظهوره عادة تدريجيا ابتداء من:
الحمى
الضعف
التوعك
قد تلي ذلك بعد بضعة أيام المعاناة من:
الصداع
التهاب الحلق
الألم العضلي
الألم الصدري
الغثيان
القيء
الإسهال
السعال
الألم البطني
في الحالات الوخيمة قد يظهر:
تورم في الوجه
سائل في الجوف الرئوي
نزيف
انخفاض ضغط الدم
وفي مراحل لاحقة:
صدمة
نوبات
حالة رعاش
غيبوبة
يصاب 25% من المتعافين من المرض بالصمم. ويسترجع المرضى في نصف هذه الحالات سمعهم جزئيا بعد شهر أو ثلاثة. ويحتمل تساقط الشعر العابر واضطراب المشية فترة التعافي، وذلك وفقا لمنظمة الصحة.
تحدث الوفاة عادة في غضون 14 يوما من ظهور الأعراض في الحالات المميتة. ويتسم المرض بوخامته بوجه خاص فترة الحمل الأخيرة ويسبب وفاة الأم و/أو الجنين في أكثر من 80% من الحالات فترة 3 أشهر الأخيرة من الحمل.
كم عدد الحالات بالمملكة المتحدة؟
تم التعرف على الفيروس رسميا لأول مرة في نيجيريا عام 1969، ولم يتم الإبلاغ عن أي حالات بالمملكة المتحدة حتى الثمانينيات، وفقا لصحيفة غارديان the guardian.
منذ ذلك الحين، تم تأكيد 11 حالة في المجموع، بما في ذلك الحالات الثلاث التي تم تحديدها الأيام القليلة الماضية.
هذه الحالات هي الأولى التي تم تأكيدها بالمملكة المتحدة منذ عام 2009.
وما عدد الوفيات؟
قالت وكالة الأمن الصحي بالمملكة المتحدة إن 4 أشخاص لقوا حتفهم بسبب الفيروس منذ عام 2000. وتوفي أحدهم عام 2000 واثنان عام 2009، وتأكدت الوفاة الرابعة يوم الجمعة.
مصدر الخبر
للمزيد Facebook